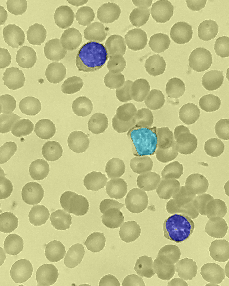
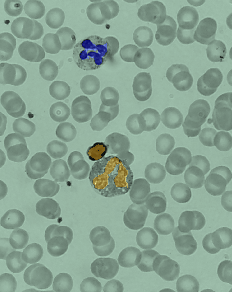

AimaLabs
Our software delivers a precise, automated analysis of peripheral blood smears through advanced computational algorithms

About Us
Our Beliefs
At AIMALabs, our mission is to revolutionize the analysis of peripheral blood smears through state-of-the-art software, leveraging the power of artificial intelligence. Our goal is to provide healthcare professionals with a reliable, efficient, and accurate tool for evaluating blood smears, facilitating early and precise diagnosis of various hematological conditions. We are committed to innovating in the field of medical diagnostics, making advanced AI technology accessible and user-friendly for laboratories and hospitals worldwide. Our vision is to enhance patient care by supporting clinicians in making more informed decisions, thereby contributing to better health outcomes. At AIMALabs, we aspire to be leaders in medical AI, continuously pushing the boundaries of what’s possible in diagnostic technology and transforming the landscape of healthcare diagnostics.

The advantages
Computerized analysis of blood smear
Your software automates the process of blood smear analysis, employing advanced algorithms to interpret and classify hematological features. This reduces the potential for human error and standardizes readings across different samples and settings.
Saves Money
By automating the analysis process, your software can reduce labor costs and the expenses associated with manual interpretation. This cost-saving benefit is especially significant in high-volume testing environments where manual analysis would require significant staffing.
Point of Care Management
Τhe software facilitates point of care testing, allowing for immediate analysis and management. This means healthcare providers can make quicker decisions about patient care directly at the site of patient interaction, which is invaluable in urgent care and critical situations.

Maria’s story
Maria, a pediatric patient of two years of age, presented to the emergency department during nocturnal hours with thrombocytopenia. The lack of an on-site experienced laboratory technician precluded the immediate evaluation of the peripheral blood smear, a diagnostic adjunct critical for patient management. Consequently, clinical decisions were deferred until the subsequent day when a proficient biomedical technician was available to perform the hematological assessment.
This case illustrates the imperative for accessible and precise hematological diagnostics. AIMALabs addresses this clinical need with its proprietary software, delivering automated blood cell morphology evaluations on a continuous basis. This innovation ensures the provision of timely and accurate diagnostic support, thereby enhancing patient care and optimizing clinical outcomes.

Our product
Blood Cell Identification




Our product
Separate nucleus and cytoplasm of blood cells

Our product
Blood Cell Μeasurment Characteristics
Red Blood Cell Surface Area



Get in Touch
E-mail: aima.cells@gmail.com
